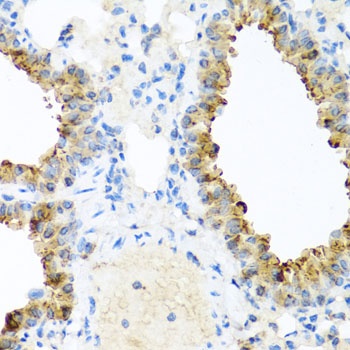
NIN Antibody抗体，orb1255944，bior

相关产品推荐更多 >
万千商家帮你免费找货
0 人在求购买到急需产品
- 详细信息
- 文献和实验
- 技术资料
- 抗体名:
NIN Antibody抗体
- 抗体英文名:
NIN Antibody
- 靶点:
NIN
- 浓度:
batch dependent
- 应用范围:
IF, IHC, WB
- 适应物种:
Human, Mouse, Rat
- 保质期:
6-12个月
- 抗原来源:
详询
- 目录编号:
orb1255944
- 级别:
科研级
- 库存:
88
- 供应商:
biorbyt
- 标记物:
Unconjugated
- 克隆性:
Polyclonal
- 形态:
Liquid
- 亚型:
IgG
- 免疫原:
Recombinant fusion protein containing a sequence corresponding to amino acids 1-287 of human NIN (NP_891991.1).
- 规格:
100 ul
别名:SCKL7, ninein, glycogen synthase kinase 3 beta-interacting protein, hNinein, ninein (GSK3B interacting protein), ninein centrosomal protein
免疫原:Recombinant fusion protein containing a sequence corresponding to amino acids 1-287 of human NIN (NP_891991.1).
分子量:Observed: 190kDa
应用注释:WB: 1:500 - 1:1000IHC: 1:50 - 1:100IF: 1:50 - 1:100
防腐剂:Liquid
纯化:Affinity 纯化
保存说明:Maintain refrigerated at 2-8°C for up to 2 weeks. For long term storage store at -20°C in small aliquots to prevent freeze-thaw cycles.
UniProt ID:Q8N4C6
Note:For research use only.

风险提示:丁香通仅作为第三方平台,为商家信息发布提供平台空间。用户咨询产品时请注意保护个人信息及财产安全,合理判断,谨慎选购商品,商家和用户对交易行为负责。对于医疗器械类产品,请先查证核实企业经营资质和医疗器械产品注册证情况。
文献和实验素所致。在粪中排出的尿胆色素原,氧化后变成尿胆色素呈黄色。通常在血液中也含少量胆色素,但因某种原因可大量出现而呈黄疸。此外,已知有数种胆色素系统的物质,如海鸥卵壳的绿色胆绿素、海藻的藻红蛋白( Phycoerythrin)、藻青蛋白( phycocya- nin),蝶的蝶绿蛋白( pteroverdin),存在于昆虫体液中的中胆绿素(认为是叶绿素的分解产物)等。
藻胆蛋白 phycobiliprotein 为含有藻胆素(Phycobilin)的蛋白质,指藻红素(phycoerythrin)和藻蓝蛋白(phycocya-nin)。
PFR暗恢复 dark reversion of PFR to PR
近红外光吸收型植物光敏色素(PTR )由于在常温下并不稳定,所以在暗处向红色光吸收型光敏色素( PR )变化,这种反应称为 PFR暗恢复。在花椰菜的花序组织仅有 PFR 暗恢复、但同时产生 PFR 暗失活的组织也不少。在组织内即使看不见 PFR 暗恢复,但若将光敏色素抽提提纯,便常可见到有 PFR 暗恢复。 PFR 暗恢复是由反应速度不同的复数反应构成,可被 NADH还原型烟酰胺腺嘌呤二核苷酸和连二亚硫酸( dithionite)等还原剂所促进,为皂苷( sopo- nin
技术资料暂无技术资料 索取技术资料











